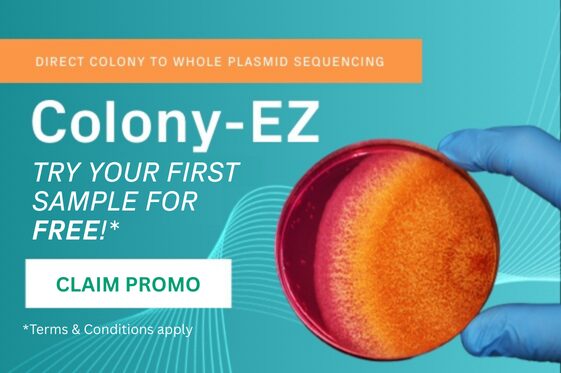
Finally, the Right Sequence – Week 8

Research Projects
The SC-ACE program was genuinely one of the best academic experiences I’ve had so far. From the very beginning, the program felt intentional and well thought out. Instead of being thrown straight into...
The 2025 Moving Targets Symposium was honestly such a cool way to wrap everything up. The day was packed with speakers from different areas of medicine and research, and it was really interesting...
Week 8 felt like the home stretch. With school starting again next week and the Moving Targets Symposium set for 8/21/2025, the pressure was definitely there. The first task of the week was...
When I came into the lab and saw that there were no colonies on any of the plates, it was a bit frustrating. No colonies meant the bacteria never took up the plasmid, which meant all the cloning work...
Week 6 was about taking all the DNA work from the previous weeks and finally turning it into something functional. The main focus was continuing to work with the pMIG-II plasmid and understanding why...
Week 5 is no different. The gel electrophoresis machine is broken. We had to borrow equipment from the other lab. Hopefully this one is better. We started by analyzing a gel from earlier in the...
The biggest, new concept I learned in week 4 was how to design restriction enzymes and perform a digestion reaction. Up until now, most of the procedures in the lab had just been protocols that I...
Week 3 started off with a mouse dissection. It was both fascinating and a little gross. I saw exactly how to collect different types of cells from organs. For example, bone marrow cells are washed out...
Part 2. I want to try to explain the first two experiments I ran without randomly throwing scientific jargon. It was finally time to learn by doing. The first experiment I did was PCR plasmid...
- 1
- 2